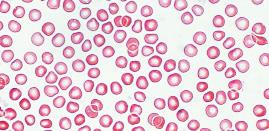

PRIMARY 6 12MONTH LICENCE DIGITAL PROJECT INCLUDED Globalaction
sample
Natural Science
• Discover all the tools people use in science. You are going to apply them throughout this book.
1What we're made of
• Learning situation. A boy talks about how his family's car breaks down during a trip. He compares mechanical breakdowns with human diseases.
• Target in action. Investigate some human 'breakdowns' to understand the cause and how to repair them.
2 Healthy eating
• Learning situation. Estelle is going to be the main dancer in her troupe. You are going to find out the advice her trainer gave her and think about why healthy habits are important.
• Target in action. Think about your own habits and make a plan to improve them and make them healthier.



• Learning situation. Jonas describes his recent mood swings. He doesn't understand why they happen. He starts thinking about the psychological and social impacts of puberty.
• Target in action. Learn about changes during puberty and write a letter to motivate Jonas.
• Learning situation. Claudia loves to make things from clay. She notices similarities between how we model clay and how rocks change in nature.
• Target in action. Build model landscapes to understand what they are like and how to protect them.
• Learning situation. Arthur wants to learn how to cook. You are going to use one of his recipes to learn about the properties of matter.
• Target in action. Analyse your favourite recipes to understand how they use matter.

• Learning situation. Helen tries to imagine her life without electricity. This situation helps you to think about how much you rely on electrical energy, and about alternatives to electricity.
• Target in action. Imagine your school doesn't have electricity. Use Helen's example to help you design a survival plan.


What are we going to learn? My STEM toolkit 3 Healthy interaction and reproduction
about
Earth
changing
108 94 72 56 32 16 8 TERM 3 REVIEW STEAM: Émilie du Châtelet and Hedy Lamarr PÁG.
5 All
matter 4The
is constantly
6 We all use energy!
SDG
LEARNING EXPERIENCE TARGET IN ACTION
Health and wellbeing Health and wellbeing Health and wellbeing
TERM 1 REVIEW STEAM: Lynn Margulis
Life on land Zero hunger Affordable and clean energy INTERDISCIPLINARY
TERM 2 REVIEW STEAM: Rita Levi Montalcini
KNOWLEDGE TO LEARN, APPLY AND INVESTIGATE
• The scientific method
• The project-based method
• Computational thinking
• The vital functions and cells
• Cell features, shapes and sizes
• Tissues in the human body
• Organs in the human body
• Systems in the human body
• The nutrition function and nutrients
• Foods and how we classify them
• The digestive system: its function and healthy habits
• The respiratory system: its function and healthy habits
• The circulatory system: its function and healthy habits
• The excretory system: its function and healthy habits
• Block-based programming
• E-learning-ICT plan
Competence-based activities
• Our chemical composition in numbers, Tissues in motion, Contest: which organ is the heaviest?
• Let’s think: An edible cell, Bits and pieces
• My job: cell biologist
Competence-based activities
• Classifying foods, Problems in the supermarket, A harmful habit, Get your blood pumping, Other ways to drink water.
• My job : nutritionist
• Let’s think: How to 'program' your dental hygiene
• Stages of the interaction function
• The sense organs: their function and healthy habits
• The nervous system: its function and healthy habits
• The locomotor system: its function and healthy habits
• The Earth's layers, minerals and rocks
• Magmatism, deformation of the Earth's crust and the rocks these processes create
• Landform modelling and sedimentary rocks
• The history of the Earth
• The reproduction function and healthy habits; puberty
Competence-based activities
• Warning! Sense rebellion!, Looking after your back, Science vs a virus
• My job : neurologist
• Let’s think: How I move
Competence-based activities
• Let's think: Making an outline about the Earth system
• Making a deck of rock cards, Volcanic and plutonic rocks in Spain, Igneous and metamorphic rocks are useful resources, Sedimentary rocks are a useful resource
• My job : palaeontologist
INTERDISCIPLINARY PROJECT · Now or never: planetary health
• Matter and its general properties
• Density and buoyancy
• The structure of matter. Atoms
• Matter states and changes
• Types of mixtures and separation methods
• Forms of energy and energy transformations
• Electricity
• Magnetism
• Types of energy sources
• Problems caused by energy use. The basic principles of aerodynamics, rolling and buoyancy
Competence-based activities
• Let’s think: Measurement algorithm
• Project: a home-made rice raft
• My job : physicist
• Projects, step by step
• Making a video game, step by step
Competence-based activities
• My job : electrician
• Magnetic train simulation, Saving electricity to make my school more sustainable
• Let’s think: projects and a video game
PROYECTO INTERDISCIPLINAR - Aprender de lo natural
INTERDISCIPLINARY PROJECT · Looking after the magic box: mysteries of the magic box
INTERDISCIPLINARY PROJECT · Green
lung: forest fires
1What we're made of
My family has lots of back luck! Whenever we take a trip, the car always breaks down. We never get to the beach. Instead, we spend our time in a car repair shop.
Our car is really old but my parents won't buy a new one – they think we can repair the old one.
My dream is to be a car mechanic! I really want to know how to identify mechanical problems quickly and how to repair them. Maybe then we can go on a real holiday!
What do you think?
Does you car sometimes break down?
What about other devices or equipment? How do you fix them?
Does your own body ever 'break down'?

Can you give an example?


Is it possible to 'repair' our bodies?


Context
An average adult human weighing 70 kg contains around 30 trillion cells. They collaborate to make our body work properly.
In this unit...
Target in action
Vamos a investigar algunas «averías» humanas para entender qué falla y cómo se pueden solucionar. 2
Follow the thread!
The vital functions and cells We are living beings
Cell features, shapes and sizes
1



We are made up of cells

16
Tissues in the human body 3
Cells group together to form tissues



Organs in the human body 4


Tissues combine to form organs
Systems in the human body
5
Organs combine to form systems

17 3
We are living beings
Humans are living beings! Our bodies work in special ways.
All living beings have three things in common: we perform the three vital functions, we are made up of cells and we have similar components.
We perform the vital functions

The nutrition function

In the nutrition function, we get substances from the environment and we use them for energy, to grow, to repair our bodies and to eliminate waste substances.
Humans are heterotrophs. That means we eat other living beings.

The interaction function

In the interaction function, we perceive changes inside and outside of our body (stimuli) and we react to the changes.
The reproduction function
The reproduction function lets humans produce offspring. They have similar characteristics to the progenitors.

Humans reproduce sexually. Two individuals with a different sex (male and female) produce reproductive cells called gametes . The gametes join together to make a new individual.
1 Do you remember what autotrophic nutrition is? In your notebook, write the difference between autotrophic nutrition and heterotrophic nutrition. What kind of nutrition do animals perform?

We need to eat and breathe to get the nutrients our body needs.
The interaction function lets us perceive stimuli and react to them.
Human offspring look similar to their progenitors.
2 Do you remember what asexual reproduction is? In your notebook, write the difference between sexual reproduction and asexual reproduction. What kind of reproduction do animals perform?
18
1
We are made up of cells!
All living beings – gigantic trees, tiny bacteria, humans and all others – are made up of cells.



A cell is the smallest component of any living being. It is the tiniest part of an organism that can perform the three vital functions.






We have similar components


All livings beings have a similar composition. We are made up of water – it contains dissolved mineral compounds. We are also made up of substances that only living beings have, like carbohydrates, protein, fats and nucleic acids.
Our chemical composition in numbers





El agua es imprescindible para que existan seres vivos ya que, sin ella, las células no pueden realizar las funciones vitales. Todos los seres vivos estamos compuestos por agua: unos tenemos más y otros menos. Fíjate en los siguientes gráficos: representan la cantidad de agua (en tanto por ciento) de diferentes seres vivos.
Living beings need water to survive. Without water, cells can't perform the vital functions. All living beings contain water. Some have more water than others. Look at the charts below: they show the percentage of water in some living beings.

1 Ordena en tu cuaderno a estos seres vivos, desde el que contiene más agua al que contiene menos. ¿Tienen alguna característica común los dos seres vivos que contienen más agua en su cuerpo?
Put these living beings in order from most water to least water. Think about the two living beings with the most water: do they have something in common?
2 If an adult human weighs 70 kg, how many kg of water does their body contain?




2 Un humano adulto humano de 70 kg ¿Cuántos kg de agua tiene en su cuerpo?
3 1 kg of water takes up 1 L of volume. How many 1 L bottles of water can you fill with the amount of water from the last question?

3 Puedes transformar el peso de agua en volumen fácilmente porque 1 kg de agua ocupa 1 l de volumen. ¿Cuántas botellas de 1 l de agua puedes llenar con la cantidad de agua que has calculado?
4 Un elefante africano adulto también tiene un 60% de agua en su cuerpo, pero pesa 6.000 kg ¿Cuántos kg de agua tiene en su cuerpo?
4 The body of an adult African elephant is 60 % water. It weighs 6000 kg. How many kg of water does its body contain? How many 1 L bottles of water can you fill with the amount of water in an African elephant's body? It's amazing!
¿Cuántas botellas de 1 l de agua puedes llenar con el agua del cuerpo de un elefante africano? Sorprendente, ¿verdad?
Take note!
Humans are made up of cells and perform the three vital functions –just like other living beings.
19 U1
60% de agua 50 % de agua
Tree
99 % water 60 % water 50 % water
Algae Human being 95 % water Jellyfish
Our body contains millions of cells.
We are made up of cells
Your body is made up of millions of tiny parts called cells. They can work independently.
Human beings, like all other animals, have many different types of cells. They perform different functions.
Human cells
Our bodies contain animal eukaryotic cells.
A human cell contains these parts:
Plasma membrane
It surrounds the cell. It provides a barrier and controls the exchange of substances between the cell interior and exterior.
Cytoplasm
The liquid inside the cell. It contains thousands of different substances and many structures called organelles
Genetic material
The substance called DNA contains the instructions for how cells work.
Human cells are eukaryotic. It means the genetic material is inside a membranous structure called the nucleus
Organelles
These structures in the cytoplasm perform different functions. There are many kinds of organelles. We are going to study two:
• Mitochondria. These rod-shaped organelles produce energy for the cell.

• Ribosomes . These tiny structures can float freely in the cytoplasm or be stuck to other organelles. They make protein.

Language Bank

Speaking. Act out the parts of a cell in groups and explain what you are doing.
Writing. Write a short story using the parts of a cell as the characters explaining what they do. Include dialogs!
Remember there are two types of cells: In prokaryotic cells, the genetic material is spread around the cytoplasm. For example, bacteria are prokaryotic cells. In eukaryotic cells, the genetic material is inside a nucleus. For example, animals and plants are made up of eukaryotic cells.
1 Why can we say that cells are alive?
2 What is a eukaryotic cell? How is it different from a prokaryotic cell?


3 What does the plasma membrane in a cell do?
4 What do mitochondria do? What do ribosomes do?
20
2
What an animal cell is like


Let’s think
An edible cell
Preparing for the task If we want to understand a structure from nature, we can make a simplified model to help us.
In this activity, you are going to use food to make a model animal eukaryotic cell. Use our suggestions, or substitute them for other ingredients. Use your imagination!


– For the membrane: a circular container.



– For the cytoplasm: lemon jelly.

– For the nucleus: a kiwi cut in half.
For the organelles: sweets, licorice, spaghetti and peanut shells.
Tip! Find pictures of animal cells on the Internet and identify the names of other organelles. Use food or other objects to imitate their shapes.
21 U1
Nucleus
Plasma membrane
Genetic material (DNA)
Cytoplasm
Mitochondria
–
Mitochondria
Plasma membrane
Cytoplasm
Nucleus
We are made up of cells
Cell size
The cells in our bodies are tiny. We need a microscope to see them.
We measure cells in microns ( μ m). One micron is one thousandth of a metre. Most cells measure between 1 micron and 100 microns across. They are really tiny!
The cells in our body have lots of different shapes and sizes. The illustration on the right shows some human cells and their approximate size.
Cell shape
As you can see, human cells are really diverse. Each type of cell specialises in a function and has the right shape for that function. For example:

• Neurons are in the nervous system. They are starshaped and have lots of extensions to touch other neurons and exchange information.
• Muscular cells are long. They can contract to move muscles.
• Epithelial cells cover organs. They are usually cubeshaped or prism-shaped. They are arranged closely with other epithelial cells.
Some human cells
150 microns (0.15 millimetres)
Spermatozoan

Epithelial cell



Ovum Red blood cells



53 microns (0.053 millimetres)
15 microns (0.015 millimetres)
7 microns (0.007 millimetres)
Muscular cell

Between 20-500 microns (0.020-0.5 millimetres)
5 Look at the cells in the illustration. Which one is the biggest? Which is the smallest?
6 The human body contains disc-shaped cells for transporting oxygen in the blood. Can you identify them in the illustration?
7 Find out what spermatozoa do (or think back to when you learned about them). Reflect: why do they have this shape?



Neuron
Between 5-100 microns (between 0.005 and 0.1 millimetres)
22 2
My profession: cell biologist



Hi! I'm Rafael and I'm a cell biologist. I study cells. I use different types of microscopes. The simplest ones are called optical microscopes. If I want to see lots of detail inside cells, I need an electron microscope. It lets me take zoomed-in pictures. Compare these two photos. The first is from an optical microscope. It shows cells around an organ. The second is from a more powerful microscope (electronic microscope). It shows a cell organelle.
1 See 'Cell size' on anayaeducacion.es and say how many millimetres there are in 25 μ m.




2 Use a ruler to measure the line below photo A. Use this measurement to help you find the height of one of the cells in the photo. Then calculate the size of the cell in microns and millimetres. Repeat with two or three more cells. Then calculate the average size of all the cells.

3 Now look at photo B. It was taken with an electron microscope. It shows a rod-shaped organelle called a mitochondrion. Use the scale below the photo to calculate the approximate size of a mitochondrion.


Take note!
Your body contains many different types of cells. They all have special features.

23 U1
0.5 μm 5 μm cell
Cells group together to form tissues
All the cells in your body have special jobs.
Tissues
Tissues are groups of specialist cells. They have a very specific job.
Epithelial tissue, muscle tissue, the blood and nervous tissue are the most common tissues in your body.
Some tissues are made up of similar cells. For example, muscle tissue. Some tissues are made up of lots of different cells. For example, the blood.
Most tissues are solid structures. For example, bone tissue or nervous tissue. Some are liquid, like the blood.
Some tissue types
Language Bank


Speaking. Draw a type of tissue and, in pairs, make questions like ‘What is the epithelial tissue going to do?’.



Writing. In pairs, write questions about the tissues. For example, ‘What type of tissue is going to create movement?’.
Made up of prism-shaped cells. They are tightly packed together. It lines the surface of the body and internal cavities (e.g. the stomach). Its main job is to protect the surfaces of the body
Nervous
Made up of star-shaped cells. They have branches for communication. It forms the nervous system. Its job is to perceive stimuli, interpret them and send instructions to the body.



Contains long, striated cells. They are also tightly packed together. It forms muscles. Muscle tissue cells can contract. Their main job is to create movement.




Blood
Contains different tyes of cells and a liquid called plasma. It forms the blood. Its main job is to transport cells and substances like nutrients and oxygen around the body.


24
Epithelial
Muscle
3
Tissues in motion
You are going to pretend you are cells in tissues in the human body. Follow the instructions to learn how the cells in each type of tissue are organised. It's fun!
How to simulate part of a tissue
1. Split the class into groups to represent each type of tissue you studied.
2. Each group researches their tissue type. Each person in the group draws one cell from the tissue on an A4 piece of paper, and colours it.
3. Each person in the group holds their picture in front of them.

4. With your group, arrange yourselves to simulate the cells in the tissue. For example:















– Stand very close to each other for epithelial tissue.

– Pretend to swim in liquid to simulate the blood. Some of you can be red blood cells and some of you can be white blood cells.
– For nervous tissue, stand in a row, stretch out your arms and open your fingers so you almost touch the head of the person next to you.

5. Simulate your tissue for the class. Then briefly expain its job and the types of cells it has.
6. Swap drawings with the other groups so you can try representing all the different tissues.
WE' RE NERVOUS TISSUE
WE'RE THE BLOOD
WE'RE EPITHELIAL TISSUE
Take note!
What happens if tissue doesn't work properly or gets damaged?




25 U1
Tissues group together to form organs
Organs are amazing!
Your left lung is smaller than your right lung because your heart needs space too.
Organs
Your organs are made up of tissues. Every organ has a specific function.
Your heart pumps blood, your kidneys clean it and your lungs perform gas exchange. Every organ is the correct size and shape for its job. Organs are usually made up of different types of tissues but some organs – the muscles, for example – have just one tissue type (in this case, muscle tissue).
Some organs like the heart, stomach and intestines have cavities. Others like the pancreas and the liver are full of cells.

Organs usually come in pairs, normally one on each side of our body. For example, two lungs, two ovaries, two eyes, etc.

Other organs are unique, e.g. we have one brain, one heart, one stomach, one liver, etc.
Your right kidney is lower than the left one.



Your stomach acid can dissolve metal.
Your brain consumes more energy than all your other organs.

The longest organ in the human body are the intestines. They are 7 m long.










Your ears keep growing throughout your whole life.
Your ear contains the smallest bone in your body.

1 What is the difference between an organ and a tissue?
2 Name one pair of organs in your body.
3 Where are most of your sense organs: in your head, your torso or your limbs? What about your nutrition organs?


4 What organs can you see when you look at someone?

5 Write around List ten organs in the human body. Classify them into unique organs or pairs of organs.


Your heart beats 100,000 times a day.
Most of your body is muscle. You have more than 600 different muscles.
26
4
Cars have complex structures for accelerating, turning and breaking, etc. Your body also contains complex structures with different functions.
Contest: which organ is the heaviest?
Imagine the organs of the human body are in a contest to see which one is the heaviest. Below are the average weights of some of the main organs in an adult human.
First contestant: Liver
Second contestant: Lung
Third contestant: Kidney
1 8 g
Fourth contestant: Brain






0 g
Fifth contestant: Heart
150 g
Sixth contestant: All the skin on the body


1 5 g
325 g
5 0 g
1 If a person weights 65 kg, what percentage of their body weight does each organ represent?




2 Show the percentages in a pie chart. Label the remaining percentage 'other organs'.


3 Study your chart. Which organ wins the competition for the heaviest organ in the body? Which organ comes second? And third?

4 Prediction The data in this activity are based on average organ weights. Everyone's body is different. What factors influence how heavy a person's organs are?
Take note!
If an organ gets damaged, it can't work properly.

27 U1
Organs combine to form systems
Can you imagine a car with the steering wheel in the boot? Or the wheels on the roof? It doesn't make sense! The organs in your body are also in sensible positions so they can work together effectively.

Organs form systems
Organs don't just work on their own. They group together to form systems so they can work together

In the respiratory system, the lungs, diaphragm, trachea and pharynx coordinate to perform respiration.


Systems in the human body, and the vital functions

Language Bank



Speaking. In groups, ask questions to make sure you understand how the human body works.

Writing. Write shortanswer questions about the human body.
Still not sure how your body works? See ‘Let me tell you’ on anayaeducacion.es.






28
Digestivo Nervous Skeletal
Female reproduction
Nutrition
Circulation
Respiration
Male reproduction Musclular
Interaction Reproduction
Excretion
5
Your body is 'balanced'
All the systems in your body work together to perform the vital functions.
When your body needs to adapt to conditions in the environment or to other changes, your body regulates itself to stay balanced
Your organs and system react to environmental changes to keep your body in balance and prevent irreversible damage.


Your body regulates itself
1 Look up the word balance in the dictionary. What does it mean if your body regulates itself to stay balanced ?
2 Give another example of how your body regulates itself in response to changes.
When it's hot outside, your body temperature increases. This can be dangerous. Your skin tells your brain that your body temperature is rising.



Your brain receives the information and sends a signal to the skin. You start to sweat. The heat in your body evaporates the sweat and your body temperature goes down.

Let’s think
Bits and pieces
Look at the picture. What three body systems can you see?








Decomposing and encoding are two computational thinking techniques.
1 Use your computational thinking skills to decompose the systems in the picture.
2 Draw a simple diagram of each system. Say what they are and what their job is.
Take note!
You can only be healthy when all your body's systems are working.
29 U1
1 2
W hat have I learned?
1 Write the meaning of cell in your notebook.
2 Which vital function does each term belong to?
a) Waste substance
b) Gamete
c) Stimulus
d) Nutrient
3 Write down four body components all living beings have.
4 Draw two human cells of different shapes. Say their functions.

5 Where is the genetic material in your cells?





6 Are all the cells in your body the same shape? Explain your answer.
7 Look at the pictures. Say at least three things you know about them:
10 Look at the pictures. What kind of tissues are they? What are their cells like?


8 Is this sentence correct? Explain your answer. 'The cells in all tissues are very similar'.
9 What do we call a group of organs that work together to perform a specific function? Give three examples.


11 Read the text:
Your muscles need lots of oxygen when you run. Your brain tells your lungs to breathe faster. It tells your heart to beat faster. Your muscles receive more blood with extra oxygen so they can work properly.
a) What systems does your body use in the example?
b) The text mentions different systems. Why is it good for them to coordinate?
c) What happens if... Imagine one of the systems stops working properly. What happens?
Don’t forget to complete your photo album for this unit on anayaeducacion.es


Traffic lights. Apply the following colour code next to each activity in your notebook.
I know the answer.
I need help.
I don’t know the answer.
30 PORTFOLIO
A B C D E
A B
TARGET IN ACTION
Investigate some human 'breakdowns' to understand how your body works.
1 Let's investigate some 'breakdowns' in the human body. In pairs, choose one illness or injury from the list. You can suggest other ones too.

2 Then work on your own to copy and complete the I think, I'm interested, I investigate… chart to explore your chosen 'breakdown' in more detail.
ILLNESSES AND INJURIES
Radius fracture

Asthma
Tendinitis


Sprained ankle
Gastroenteritis

Pollen allergy


Short-sightedness
I investigate I think
What do you already know about the injury or illness? What are the symptoms?
What type of cells, tissues or organs does it affect? Is there a treatment to 'repair' it?


What questions do you have?
I’m interested H

What do you want to know about your chosen injury or illness?
Find information to answer your questions. Write down any interesting information you find.
3 Compare your chart with your partner. Share your conclusions. Prepare a short explanation of the 'breakdown' and how to 'repair' it. Lastly, present your explanation to the class (you can use pictures to support what you say).
o w have I learned?
1 You completed the first unit of the book. In your notebook, reflect on your feelings at these times:
When you started the new school year.
When you discovered new concepts.
When you organised your work and study time.
When you worked in a group.
U1 31
2 Healthy eating
I can't believe it! They chose me to be the lead dancer in my hiphop troupe! That means I'm going to dance in all the competitions. I'm so excited, and nervous too!
I'm a professional now, and that means I need to eat properly to stay fit. Dance is really important to me, so tomorrow I'm going to follow a new plan to transform myself.
What do you think?
What do you think about Estelle's plan? Do you think her ideas will help her be a better dancer?

Read the Context. Do you think a one-day plan is enough to look after our bodies?
If someone doesn't do sport, do they need to follow healthy habits and eat healthily?
Why? Context


A habit is an action you do regularly or every day. It can have big long-term effects.


In this unit...
Target in action
Think about your own habits and make a plan to improve them and make them healthier.
Follow the thread!
The nutrition function and nutrients
1

What is nutrition?
Foods and how we classify them
2
Where nutrients come from

32
1. Only eat fruit and vegetables for one whole day. Healthy eating is important!


2. Sleep for seven hours so I have time for an early-morning run. I can go for two hours (but I don't usually run, so let's see how long I last...).
3. Drink lots of energy drinks after my run to recharge my batteries.





33 3 The respiratory system: its function and healthy habits Respiration and respiratory health 5 The circulatory system: its function and healthy habits Circulation and circulatory health 6 The excretory system: its function and healthy habits Excretion and excretory health 7 How can you eat healthily? Diet and healthy eating 3 Digestion and digestive health The digestive system: its function and healthy habits 4
What is nutrition?
Your body needs nutrition do active things like hip-hop. Thankfully, your body has everything it needs for this job. Do you know how it works?
The nutrition function
Nutrition is all the processes we use to get matter and energy to build, repair and maintain our bodies.
There are three processes in the nutrition function:
• We get nutrients from food and oxygen from the air we breathe.
• Our body transports nutrients and oxygen to all cells so they can work.
• We excrete the waste products and carbon dioxide from cell activity.


Study the systems in the human nutrition function in the picture.
1 Write around Work in groups of three. Copy the outline below onto a piece of paper. Fill in the blanks with the words and phrases underneath. Then compare your outline with the other groups.
.... ....
Circulatory system
Cells
The digestive system

Mouth
Salivary glands
Oesophagus
Liver
Large intestine
Circulatory system

Stomach
Pancreas

Small intestine
Respiratory system
Respiratory tract
Heart
Lungs
Digestive system
Oxygen
Carbon dioxide
Respiratory system

Waste substances
Blood vessels
Diaphragm

The excretory system

Kidneys

Excretory system
Nutrients
Ureters
Urethra
Bladder
34
1
Nutrients
Nutrients are substances we get from food. They give us matter and energy so our cells can work properly.
These are the main nutrients:
• Carbohydrates or sugars. Our cells need these 'fuels' for energy.


• Lipids. They perform different functions. For example, fats provide energy and we can store them. We need other lipids to form structures, like the plasma membranes of cells.

• Protein. We need this to build our cells, tissues and organs. Protein also regulates cell activity.

• Vitamins and minerals. They regulate our overall cell function.
• Water. It's the main component of cells. Most cell processes happen in the watery environment called cytoplasm, so your body can't survive without water. We also need water to transport substances like nutrients around the body.
Nutrient functions
Sugars and lipids give us energy.
We need protein and lipids to build cells.

Vitamins, protein and minerals regulate our body.
All cell processes happen in water


2 Review this page and complete the table. Draw an X to match the nutrients with their functions. Body-building
Take note!
35 U2
Four systems in your body work together to get and process nutrients: the digestive system, the respiratory system, the circulatory system and the extretory system.
function Energy-giving function Body-regulatory function
Vitamins
Protein Fats Water
Minerals Carbohydrates
Where nutrients come from
Language Bank


Speaking. Talk about what you ate yesterday.
We

get most of
our
nutrients
from
food. But some foods have more nutrients than others.
Foods
Foods contain the nutrients our body needs to work properly.
Some foods have just one type of nutrient. For example, oil is made up of fat. Some foods have several different types. Fore example, pulses contain protein, carbohydrates, vitamins and mineral salts.
Classifying foods
There are different ways to classify foods. These are the most common ways:
• By the function of their most abundant nutrients
• By how processed they are (the NOVA classification).
Foods and their functions
We can classify foods based on the functions of their nutrients:
• Energy-giving foods contain mostly carbohydrates or fats. Cereals, flour, pasta, bread, potatoes and sugar contain carbohydrates. Oils and butter contain lots of fat.

• Body-building foods contain lots of protein. They include meat, fish, eggs, milk and milk derivatives, and pulses.
• Body-regulatory foods contain lots of vitamins, minerals and plant fibre. They help your body work and stop you getting sick. Fruit and vegetables are body-regulatory.
Writing. Write a diary entry about what you ate on your last birthday.
Classifying foods
Peter and Alexis aren't sure which foods on the school menu are energy-giving, bodybuilding and body-regulating. Can you help them?
Apple

Water: 85.7 g
Protein: 0.3 g
Lipids: 0 g
Carbohydrates:
12 g
Fibre: 2 g
Semi-lean meat:

Water: 62.3 g
Protein: 21 g
Lipids: 16.7 g
Carbohydrates: 0 g
Fibre: 0 g
Bread

Water: 10 g
Protein: 15 g
Lipids: 2.5 g
Carbohydrates:
70 g
Fibre: 2.5 g
Yoghurt

Water: 87.9 g
Protein: 3.7 g
Lipids: 2.7 g
Carbohydrates: 4.4 g
Fibre: 0 g

Dried fruit and nut
mix:
Water: 4.6 g
Protein: 22.9 g
Lipids: 54.1 g




Carbohydrates: 7.9 g
Fibre: 7.5 g
Chard

Water: 87.5 g
Protein: 2 g
Lipids: 0.4 g
Carbohydrates: 4.5 g
Fibre: 5.6 g
1 Read the food information cards. Then classify them and explain your reasons.
2 Do some foods belong in more than one group? Give an example and explain.
36
2
Foods and how processed they are
The NOVA classification puts foods into four groups based on how processed they are.
• Group 1: Fresh or minimally-processed foods such as meat, fish, milk, yoghurt, flour and pasta.
• Group 2: Processed culinary ingredients like oils, seasoning like salt, pepper and spices, and sweeteners like sugar and honey.


• Group 3: Processed foods. These are foods from group 1 with an added ingredient like salt or oil. They also include cooked and fermented foods, bread and some drinks.
• Group 4: Ultra-processed foods and drinks. These foods are made using industrial processes. They contain additives, sweeteners, and flavour/texture enhancers.
Problems in the supermarket
Look at the foods in this supermarket: they are grouped together according to the NOVA classification. The customers aren't sure about the groups. Can you help them?

1 Match each shelf (1 to 4) with a NOVA category. Explain your answers.
2 Some foods aren't on a shelf yet. Answer these questions about them:
a) What is the main ingredient?
b) What is the food's function?

c) What shelf does it belong on?
3 Read the lists of ingredients. What do you notice about the amount of ingredients and the NOVA classification? Which food contains the most ingredients? Which food contains the least ingredients?
Salmon cakes. Ingredients: salmon, salt, soy protein, acidity regulator, stabiliser, aroma, antioxidants, colourants.
Fresh salmon. Ingredients: salmon.
Salmon fillets. Ingredients: salmon, salt.



Take note!
There are different types of foods. When we understand them, we can make healthy choices.
37 U2
Learn more about the NOVA classification system and food labelling on anayaeducacion.es
A B C
How can you eat healthily?
A good diet is essential for your body to work properly. Can you be healthy if you eat healthy foods just once?
Diet
If you want to be healthy and meet your body's needs, you need to follow a good diet.
Your diet is all the food portions you eat in a typical day.
A portion is an approximate amount of food in one meal. Look at the examples on the right.
Diet and healthy eating
A healthy diet contains appropriate amounts of all the nutrients you need.
You can combine lots of different foods to achieve a healthy diet. One person's healthy diet might be different from someone else's.
A healthy diet meets each individual person's needs. These needs depend on a person's:
• age.
• weight and height.
• sex.
• level of mental and physical activity.
• geographical location and the season. We need different nutrients depending on the climate where we live. For example, people who live in cold countries need more energy-giving foods.

• special circumstances, such as pregnancy, breastfeeding, illness, etc.




Portion sizes
One tablespoon holds 20-30 ml.


One knob of butter is around 10 g.
One glass contains 200-250 ml of liquid, e.g. milk or water.

One slice of bread is around 30 g.



A handful of nuts is around 20 g.
One whole piece of fruit.
One slice of fruit.
1 Do you think the expression 'to be on a diet' is a good way to describe someone who wants to lose weight?
2 Can two people have different healthy diets if they are the same age, sex, have the same level of physical activity and live in the same place? Explain your answer.
3 List the portion sizes of the foods you ate for dinner last night.
4 Look up the adjective diet. Can some foods be diet foods? Explain your answers.


38
3
My job: nutritionist



I'm Berta and I'm a nutritionist. I'm a health professional and I specialise in human nutrition, food and diet. I design healthy diets for lots of different people. Lots of people think a diet is just for losing weight, but that's not true! Our diet is all the food we eat in a typical day. We are all on a diet! The real challenge is to eat foods that are good for our own bodies. Below are the requirements for a healthy diet:
It is sufficient. In other words, it meets our energy needs based on our activity level, weight, age, etc.
It is complete. It contains all the nutrients we need and appropriate amounts of these nutrients.
It is balanced. It contains a variety of good-quality foods, including foods from group 1 of the NOVA classification.








It is safe. That means it doesn't contain any toxic substances or carcinogens.


It is acceptable. We need to enjoy eating the foods in our diet.
It is adapted to social, cultural, environmental and individual needs.




It is social and affordable. In other words, our diet needs to promote social interaction and social harmony at mealtimes. It also needs to be financially realistic.
It is sustainable. We need to think about pollution caused by our diet and the resoureces needed to produce the foods we eat. A sustainable diet is based on local foods. It contains more plant-based foods and less meat.
Preparing for the task Now you know what a healthy diet looks like. Can you help me with my work?
1 Let's look at the Mediterranean diet. In groups, go to anayaeducacion.es and study the resource about this diet. Score the Mediterranean diet 1 to 5 for each requirement on the list above.
2 Compare your scores with the other groups. What are your conclusions? Is the Mediterranean diet healthy?

3 Imagine you are responsible for feeding your family for one whole day. Design a Mediterranean menu for the day. Include all five recommended meals.
4 Find out what gluten is and which foods contain it. Is the Mediterranean diet suitable for someone with a gluten intolerance? Explain your answer.
39 U2
How can you eat healthily?
Diet recommendations

There are lots of ways to represent a healthy diet or lifestyle in pictures. Two common ways are the eating pyramid and the food wheel
The healthy eating pyramid
This trianglular diagram shows healthy habits and healthy foods to support a healthy lifestyle. Study the pyramid and the notes:
The healthy eating pyramid
Dairy: 2-3 per day











Others: < 3 per day


Vegetables: 2-3 per day





Fruit: 3-4 per day




Eat according to level of physical activity
To learn more about healthy eating, watch the video ‘Let me tell you’ on anayaeducacion.es















We should only consume the foods at the top of the pyramid occasionally. The lower levels show foods we can eat more frequently.







Healthy lifestyles are at the bottom of the pyramid.

40
3
Proper hydration Healthy cooking Exercise
Daily Occasionally Weekly Healthy lifestyles
The food wheel

The food wheel shows the foods we need to include in our diet and the quantities. The wheel includes six food groups, but sometimes experts change the food wheel to include new discoveries about nutrition.
Colors Food group Function Group II. Oils and fats, e.g. butter. These foods have lots of lipids and give us energy.





I, II Energy-giving
III, IV Body-building
V, VI Body-regulatory
Group I. Grains and their derivatives (e.g. bread and pasta), potatoes and sugar. These foods have lots of carbohydrates and give us energy.









Group VI. Fresh fruit. It contains lots of mineral salts and vitamins. It helps regulate our bodies.









5 Compare the food wheel and the healthy eating pyramid. How is their information different? How is their information similar?
6 Use the wheel and the pyramid to help you design a menu for one week. Include 5 meals every day: breakfast, mid-morning snack, lunch, afternoon snack and dinner.

Group III. Meat, fish, eggs, pulses and nuts. These foods have lots of protein and help build our bodies.
Group IV. Milk and its derivatives, e.g. cheese. These foods have lots of protein and help build our bodies.






Group V. Vegetables and leafy greens. They contain lots of mineral salts and vitamins. They help regulate our bodies.



7 Imagine a six-year-old child asks you for healthy diet advice. What five things can you tell them using the information from the food wheel and the eating pyramid?


Take note!
There are simple recommendations for a healthy diet, but we all have different needs.

41 U2
Digestion and digestive health
We digest food to access the nutrients it contains. Do you remember how your body performs digestion?
Healthy eating is easier when we understand how our digestive system works. Good digestion helps prevent illness and damage to your digestive system.
The digestive system and digestion
You already learned that the digestive system is made up of organs that get the nutrients we need from the food we eat.
It performs three processes: it digests food, it absorbs nutrients and it excretes waste.

Digestion transforms food into nutrients. These get absorbed and transferred to our blood. Our body excretes substances we don't need.
Your digestive system absorbs almost all the substances in food. These include nutrients but also additives, medicines, drugs and toxic substances like alcohol.
1 Is this sentence correct? Explain your answer: 'The digestive system proceseses food and only absorbs nutrients and good substances.'
2 Which part of the digestive system: makes the chyme?; absorbs nutrients?; forms faeces?



Digestion step by step
Your teeth grind up food. It gets mixed with saliva to form a bolus
The food moves through the oesophagus to the stomach.

Go to anayaeducacion.es to see the digestion system in detail.

In your stomach, the bolus gets mixed with gatric juices. It turns into the chyme and moves to the small intestine.


In the small intestine, the liver and pancreas add bile and pancreatic juice to help break down the food. The result is a mushy substanace called the
Digestive nutrients travel through the intestinal walls and into the blood. This process is called absorption
The large intestine absorbs water, mineral salts and some vitamins. Our body turns unabsorbed substances into faeces and excretes them through the anus.

42
4
1 3 5 2 4
Healthy habits for your digestive system
Follow these habits to look after your digestive health:
• Follow a balanced diet to get enough nutrients. Eat fruit and vegetables every day.
• Eat foods containing plant fibre to help food move through your intestines.


• Eat slowly and chew properly.
• Eat four or five small meals every day. Try to always eat at the same time. Eat your last meal of the day at least two hours before you go to bed.
• Only eat what you need . This makes digestion easier. Limit your consumption of salt, chocolate, spicy sauces, coffee and fizzy drinks. They are not good for your digestive system.
• Wash fresh foods and wash your hands before and after meals to prevent infectious diseases and food poisoning.




• Follow good dental hygiene . Brush your teeth after every meal to prevent tooth decay.
How to 'program' your dental hygiene
Everyone needs to brush their teeth properly after they eat. You can use a computational thinking technique as a fun way to analyse if your dental hygiene is good. Which technique? Algorithms! Let's study the steps for brushing your teeth and find out if you are doing something wrong.
Imagine you are sitting at home on the sofa and it's time to go to the bathroom to brush your teeth. Write all the steps you need to follow, starting from the sofa and all the way to the end of the process.
When you finish, go to anayaeducacion.es and find the resource called 'Dental hygiene step by step' to check if you know how to brush your teeth properly. Change your algorithm to improve your dental hygiene.





1. I get up from the sofa.
2. I walk foward two steps.
3. I turn left and walk forward seven steps to the door.


4. I turn right and walk foward eight steps to the bathroom door.


5. Complete the algorithm with all the other steps you need to follow.
3 What habit does the photo show? Write a text to explain why this habit is important for your digestive health.
Take note!
You probably do actions every day to support your digestive system. Can you give some examples?

43 U2
Let’s think
Respiration and respiratory health

Oxygen is a really special substance. It's a gas! Is it possible to 'consume' oxygen?
When your body has enough oxygen, you have more energy and your brain works better. This is only possible if you know how your respiratory system works and if you follow good respiratory habits.
The respiratory system and breathing
You already know that the respiratory system is made up of organs that perform respiration.



Respiration is the process our body uses to get oxygen (O2) from the air and transport it to the lungs. We also expel the waste carbon dioxide (CO 2) from our cells.
Look at the stages of respiration in the illustration below.
Go


Language Bank




Speaking. Think about the last time you caught a cold. What habits did you not follow?
with lots of O2
CO2 leaves
with lots of CO 2
Air filled with O2 enters
Diaphragm Diaphragm

The diaphragm contracts and lowers. The lungs expand and fill with air through the nostrils and the respiratory tract.
The inhaled air has lots of oxygen. Some oxygen travels through the walls of the alveoli and into the blood. The blood has lots of carbon dioxide. It releases some of this waste into the alveoli.


44
5 Respiration step by step
After the gas exchange, the air in the alveoli has less oxygen and more carbon dioxide. The diaphragm relaxes and rises. It compresses the lungs. They release air through the respiratory tract and into the environment. to anayaeducacion.es to see the respiratory system in detail. Inhalation Gas exchange Exhalation 1 2 3
Air filled with CO 2 leaves
Blood Blood
O2 enters O2
Writing. Write down what your classmates said they didn’t do.
Healthy habits for your respiratory system
Follow these habits to look after your respiratory health:
• Inhale through your nose. Your nostrils warm and humidify the air before it reaches your lungs.

• Do exercise every day to improve your lung capacity.
• Avoid polluted places. Ventilate spaces where you spend lots of time.

• Wear a scarf or similar items in winter to stop very cold air entering your respiratory tract. Cold air increases your risk of catching respiratory illnesses.
• Cover your mouth and nose when you sneeze or cough to stop pathogens from spreading.


• Wear a face mask to protect yourself from dust. Also wear one in busy places if there is an epidemic or a pandemic.
• Avoid cigarette smoke Smoking is a really bad habitat for your respiratory system.



A harmful habit
We know smoking is really harmful for our health, but lots of people smoke anyway. Find out how smoking damages your health. Then organise a campaign to convince young people not to smoke.
1 Work in groups. Watch 'The risks of smoking' on anayaeducacion.es and take notes.


2 Use the information to make a six-page pamphlet:
1 What habit does the photo show? Write a text to explain why this habit is important for your digestive health. Respiratory

Take note!
Your respiratory system takes in oxygen and releases carbon dioxide all the time. You need to look after it.
45 U2
illnesses linked to smoking.
Other
illnesses linked to smoking.
How to avoid the temptation to smoke.
The cover page. Include a slogan and a picture to motivate people to smoke smoking.
The history of smoking. The components of tobacco smoke and their effects.
Circulation and circulatory health


All our cells need nutrients to work properly. Do you remember how nutrients travel around the body?

The circulatory system and circulation

Your circulatory system transports nutrients around your body and removes waste substances What happens if your circulation is blocked? Your heart is the engine of your circulatory system. What happens if your heart stops working? When you know how circulation works, you can follow healthy habits to prevent these problems.
Blood flow
Blood flow is the movement of the blood around the body, starting and ending at the heart.
Blood in the human body flows around two circuits: the pulmonary circuit and the systemic circuit.
1 Pulmonary circulation connects the heart and lungs. Blood filled with carbon dioxide leaves the heart and travels to the lungs. There, it releases carbon dioxide and takes oxygen back to the heart.

2 Systemic circulation connects the heart and the other organs in your body. It transports nutrients and oxygen, and it removes waste products and carbon dioxide from your cells.
Your heartbeat is a continuous rhythmic movement that happens when your heart muscles contract and relax. It pumps blood through your blood vessels.
Blood flow
1 Pulmonary circulation
1 In your own words, say what the heart does in the circulatory system.
2 Can your arteries carry deoxygenated blood? Explain your answer.
2 Systemic circulation
Go to anayaeducacion.es to see the circulatory system in detail.

3 Capillaries are small blood vessels with very thin walls. Why are they like this?

46
6
Vein Artery
Lungs
Artery
Vein
Healthy habits for your circulatory system
Follow these habits to look after your circulatory health:
• Do moderate physical exercise every day. The walls of your heart are made up of muscles. You need to use these muscles to keep them strong.
• Follow a varied and balanced diet. Avoid fatty and sugary foods because they can damage your heart and blood vessels.

• Drink water . Your blood contains a lot of water.
• Maintain a healthy weight for your physical characteristics and level of physical activity. Being overweight is bad for your heart.

• Avoid alcohol and tobacco. If you inhlale or consume toxic substances, they travel into your blood and they can harm your blood vessels and heart.
• Avoid stressful situations and get enough sleep.

Get your blood pumping
You are going to think scientifically about heart health and physical exercise. Find a partner. Get ready to exercise!
Ask your partner to relax in a chair. Measure or 'take' their pulse. To do this, use your index and middle fingers to press lightly on the side of their neck. Can you feel rhythmic pulsations? Count the number of pulsations in one minute. Now ask your partner to do 20 squats and take their pulse again? Swap roles and repeat.
1 What are the pulsations you can feel?


2 Does the rhythm change after physical exercise? How? Is it slower or faster?

3 Why does the rhythm of your pulse change after physical exercise?
4 You know that your heart is an organ with muscular walls – your cardiac muscle. How do you think physical exercise affects your cardiac muscle?
4 What habit does the photo show? Write a text to explain why this habit is important for your circulatory health.


Take note!
Your circulatory system is always working. You can help keep it healthy.
47 U2
Excretion and excretory health




Your organs produce waste. Too much waste in your body can be toxic. How does your body remove waste?
When you understand how excretion works, you can avoid problems with your excretory system and follow healthy habits.

The excretion function lets your body remove waste substances left over from the nutrition function.
The excretory system and excretion
Your excretory system is made up of the organs your body needs to eliminate waste products from cells and from the blood.
These are the main stages of excretion:
How urine forms

2
Speaking. In groups, ask questions to know what healthy habits you didn’t follow the last time you got a stomach ache.

Writing. Write down the questions and ask them to your family and friends.
Your body has other systems for removing waste. The sweat glands in your skin eliminate substances via sweat. The digestive system eliminates waste substances (faeces) left over from digestion. The respiratory system eliminates carbon dioxide.
Go to anayaeducacion.es to see the excretion system in detail.
1 List all the waste products from the human body. Which organ or system eliminates them?
2 List all the different ways your body excretes water. Do any of the processes on your list have other functions too?

48
7
5
1 Blood carries waste substances from all around the body and enters the kidneys.
The kidneys filter the 'dirty' blood and make urine.
3 The 'clean' blood leaves the kidneys.
It leaves the body through the urethra.
Ureter
4 The urine travels through the ureters to the bladder.
Language Bank
Healthy habits for your excretory system
Follow these habits to look after your excretory health:
• Drink plenty of fluids , especially water. This stops your body producing very concentrated urine. It also prevents bladder and kidney stones, and infections.


• Follow good personal hygiene. This helps prevent bladder infections.
• Avoid tobacco and alcohol and avoid exposure to toxic substances in general.
• Do not take pain medication without a prescription When people abuse over-the-counter pain medication, they can harm their kidneys.
• If you need to urinate, don't hold it in. If you don't empty your bladder when you need to, it can become sick or damaged.
Other ways to drink water
As part of the excretion process, your body eliminates water in the form of urine and sweat. You need to drink enough water.

You get some water from the foods you eat. Look at the table of foods and their water content.
1 Order the foods according to their water content. Then answer the questions:
a) What types of foods contain more water?
b) What types contain less?
c) Why do you think this is?
2 What does it mean if a watermelon contains 95 ml of water per 100 g of food? How much water do you consume if you eat 300 g of watermelon? And if you eat 1 kg of watermelon?

3 Use the NOVA classification to group the foods together. Then compare their water content.
4 Is it good for our excretory health to eat natural or minimally processed foods? Explain your answer.


3 What habit does the photo show? Write a text to explain why this habit is important for your excretory health.




Take note! ml of water per 100 g of food Watermelon 95 ml Bread 35 ml Cucumber 92 ml Orange 86 ml Milk 95 ml Biscuits 9 ml Mature cheese 39 ml Industrial pastries 15 ml Chicken 70 ml Tinned sardines 60 ml

49 U2
Our body needs nutrients, but it also needs to eliminate waste. Follow healthy habits to look after your excretory system. Food
W hat have I learned?
1 List the three processes in the nutrition function.
2 List the systems in the nutrition function.
3 What are the differences between a nutrient and a food? Give two examples of each.
4 Find the odd one out in each group. Explain your choices.
a) vitamins, water, butter, carbohydrates, protein
b) kidney, ureter, bladder, nephron, alveoli, urethra
c) stomach, oesophagus, small intestine, lung, liver
5 Classify these foods into energy-giving, bodybuilding and body-regulating. Some foods might belong in more than one category: bread, lettuce, eggs, potato, cheese, mandarin
6 Complete the sentence about the functions of the circulatory system: The circulatory system transports ... and ... to all cells in the body. It removes ... and other ... from the cells.
7 Where do these nutrition processes happen? Explain what they do:
a) Nutrient absorption
b) Oxygen absorption
c) Urine formation
d) Carbon dioxide elimination
8 Are these statements true or false? Correct the false ones:
a) Air enters our lungs when we exhale.
b) We absorb most nutrients in our intestines.
c) The excretory system eliminates waste products from the blood, including carbon dioxide.


9 Why are these habits important?
a) Washing your hands before you touch food.
b) Eating slowly and chewing properly.
c) Drinking lots of water during the day.

10 Look at the pictures. What healthy habits do they show? What bodily system does each habit belong to?
11 In this unit, you learned lots of healthy habits to look after your nutrition function. Write down habitats for looking after at least two systems from your nutrition function. Then list the top five habits for a healthy nutrition function in general.
12 Alcohol is a toxic substance. In this unit, we encouraged you to avoid it. Research this substance and briefly explain how it can harm your body.
Don’t forget to complete your photo album for this unit on anayaeducacion.es



Traffic lights. Apply the following colour code next to each activity in your notebook.
I know the answer.
I need help.
I don’t know the answer.
50 PORTFOLIO
A B C D
TARGET IN ACTION
Think about your own habits and suggest ways to improve them.
You are going to investigate how to improve your habitats to look after your nutrition function. Follow these steps

1 Use the mirror technique to compare your real habits with the habits you learned in this unit. First, copy and complete the chart. Don't worry if some of your habits are different. It's normal!
Ideal healthy habits
My real habits
Which ideal habits are different from your real habits?
Which ideal habits are similar to your real habits?
2 Look at the differences between your real habits and the ideal habits. Can you think of easy ways to improve your habits? Write at least five ways to improve your habits. Try to be realistic. Only write down things you can achieve.
3 As a class, go back and read Estelle's plan from the start of the unit. What advice can you give her for looking after her body to become a good dancer?
Which of your real habits are different from the ideal habits? H
o w have I learned?

1 In your notebook, copy the table on the right. Score each sentence from 1 to 5. 1 means you completely disagree and 5 means you completely agree. Then answer the questions.
a) Which sentence do you agree with the most? Why?
b) Which sentence do you disagree with the most? Why?
c) Was this unit useful for you? Write a short text to explain your opinion.
I know more healthy habits now.
I enjoyed learning about the nutrition function.
I am going to tell my friends and family to follow the healthy habits from this unit.
I want to know more ways to improve my health and the health of my friends and family.



U2 51
Ability
Score
Different habits Similar habits
Different habits
What bodily function does each picture show? Match the words to the pictures.



Find the hidden tissues, then say what their main function is. What organs are they from?

The liquid that makes up the ... contains organelles and many other substances.


The ... contains information the cell needs to work.
The ... is a barrier to control the exchange of substances between the cell interior and the exterior environment.

Imagine you go to the supermarket with three special bags: one bag for energy-giving foods. one bag for body-building foods. one bag for body-regulating foods. What things can you put in each bag?
Which system in your body do these words belong to?
REPASO REVIEW 3 5 4
1 2 C Sexual Stimuli Heterotrophic Gametes Nutrients Getting energy Reacting
E S T I R A M U A N E R V O E H L P L T A O I I S Filtration Ureter Urine Urethra Heartbeat Artery Transportation Vein Inhalation Diaphragm Carbon dioxide Gas exchange U S O N A S C L E A R
You talked to your friends and now you have a question: do they look after their health? Why?

I always eat fast. I don't have time.
I never wear a scarf. I don't like how it feels.
I always forget to drink water. I'm never thirsty.
When I'm watching a great movie, I ignore the urge to go to the bathroom. I don't want to miss anything!
Discover the mystery scientist

Which famous scientist made these notes? Use the clues to help you.



One from each kingdom:
Clues

I was born in the USA in 1938.
I wrote the theory of endosymbiosis.



I went to university when I was 16. I loved to study microorganisms.



TRIMESTRE TERM 1 6
the code to discover the mystery scientist.
Scan
sTEAM
©
All rights reserved. No part of this publication may be reproduced, stored in a retrieval system, or transmitted, in any form or by any means, electronic, mechanical, photocopying, recording, or otherwise, without the prior permission of the publishers.
GRUPO ANAYA, S.A., 2023 - C/ Valentín Beato, 21 - 28037 Madrid.